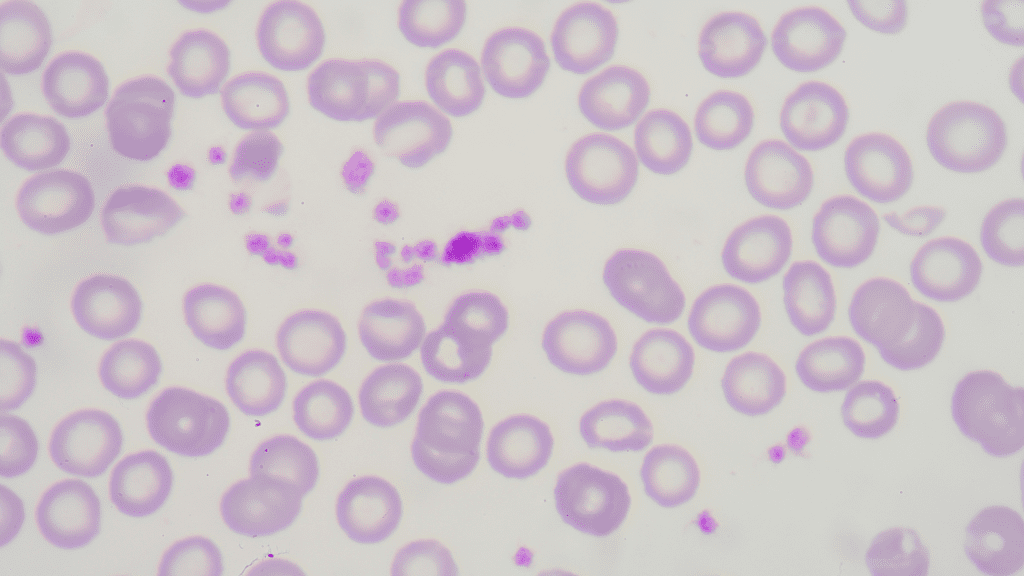

Tem alguma dúvida?
Clica no botão abaixo e fala com a gente pelo WhatsApp

e seja referência em Hematologia no Laboratório

tudo da Hematologia Laboratorial, de forma descomplicada, prática e objetiva. Contemplando Leituras e Revisões de Lâmina com casos de doenças hematológicas benignas (como Anemias e PTI) e malignas (como Leucemias e Linfomas) e muito mais.

- Coleta do material
- Ordem e Análise dos tubos
- Hemólise e Lipemia
- Volume do Tubo e Recoleta
- Erros pré-analíticos

- Prática de Esfregaço Sanguíneo
- Prática de Coloração com May-Grunwald-Giemsa
- Análise da Lâmina por microscopia

- Valores de referência da série vermelha, branca e plaquetas
- Valores de referência em RN, crianças, adultos e idosos.

- Leitura de Lâminas com morfologia de células normais e anormais do sangue
- Casos clínicos reais com dados do hemograma, leitura de lâminas com contagem de células (01 a 100)
- Diferenciação prática das células do sangue

- Eritropoese e Hemácias
- Anemias: conceito, tipos, sintomas e parâmetros
- Eritrograma: detectando a anemia
- Morfologia Eritrocitária
- Anemia Ferropriva
- Anemia megaloblástica
- Anemia Normocítica
- Anemias Hemolíticas e Reticulócitos
- Anemia Falciforme
- Talassemias
- Outras Anemias Hemolíticas

- Introdução aos Leucócitos
- Neutrófilos
- Linfócitos
- Eosinófilos
- Monócitos
- Basófilos
- O que são e como são formadas
- Plaquetograma
- Plaquetopenia
- Contagem de Plaqueta na Prática
- Pseudoplaquetopenia e Medidas Corretivas
- Trombocitose

- Introdução às Neoplasias Hematológicas
- Leucemias Agudas - Conceito, Clínica e Diagnóstico
- LMA: hemograma, morfologia e casos clínicos
- LLA: hemograma, morfologia e casos clínicos
- LMC: hemograma, morfologia e casos clínicos
- Neoplasias Mieloproliferativas: hemograma, morfologia e casos clínicos
- LLC / Neoplasias Linfoproliferativas: hemograma, morfologia e casos clínicos
- Linfomas: hemograma, morfologia e casos clínicos
- Morfologia das Leucemias Agudas
- Morfologia na Doenças Mielóides Crônicas
- Morfologia na Doenças Linfóides

- Base da Automação em hematologia
- Eritrócitos
- Leucócitos
- Equipamentos Hematológicos
- Critérios de Revisão

- Fisiologia da Coagulação
- Trombose
- Laboratório e Coagulação
- Anticoagulação
- CIVD e Caso Clínico

- Introdução à Imuno-Hematologia
- Sistema ABO
- Sistema Rh

Casos clínicos com hemograma e morfologia de doenças como:
- Anemia Falciforme
- Púrpuras
- Leucemia Promielocítica
- Mononucleose com Linfócitos Reativos
- Talassemia
- Trombocitemia essencial
- LMA, LLA, LMC, LLC
- Eliptocitose hereditária
- Anomalia de Pelger Huet
- Linfomas
- e muito mais!



Participe do grupo exclusivo de alunos no WhatsApp e tire as dúvidas de seus casos e exames em tempo real, direto com o professor.
Treinamentos Práticos, Online e Ao Vivo, de Leitura de Lâminas e discussão de Casos Clínicos reais.
Estará de plantão? Tudo bem! Esses treinamentos também serão gravados e disponibilizados para você!
Com microscópio acoplado ao computador, você fará interpretações de diferentes Hemogramas junto com o professor!




Você adquire agora o acesso completo ao Curso de Hematologia Laboratorial na condição especial de R$297 e tem 7 dias para avaliar.
Se por algum motivo você achar que este material não é para você, ou que não vale o investimento, receberá seu dinheiro 100% de volta! Basta enviar uma mensagem para nós dentro do prazo de 7 dias.
Como você pode ver, o risco é todo nosso!
Sim! Você pode acessar o curso em qualquer lugar do mundo, em todos os dispositivos: celular, computador, TV ou tablet.
Sim! Assim que você finaliza o curso, recebe o certificado de 40 horas automaticamente em seu email.
Você tem 12 meses para fazer o curso, ver e rever as aulas quantas vezes quiser!
Sim!!! Utilizando o recurso da Tele Hematologia, vamos fazer leituras de lâminas na prática com vocês, com diversos casos clínicos reais!
Os treinamentos vão acontecer 1 vez por mês, normalmente à noite. Combinamos as datas com vocês no grupo exclusivo de alunos.

fundada em 2019 pelo Prof. Dr. Luiz Arthur Calheiros Leite, a Escola Brasileira de Hematologia Laboratorial (LaHemato EaD) já compartilhou conhecimento com mais de 5.000 alunos do Brasil e exterior, em mais de 10 diferentes cursos da área laboratorial.